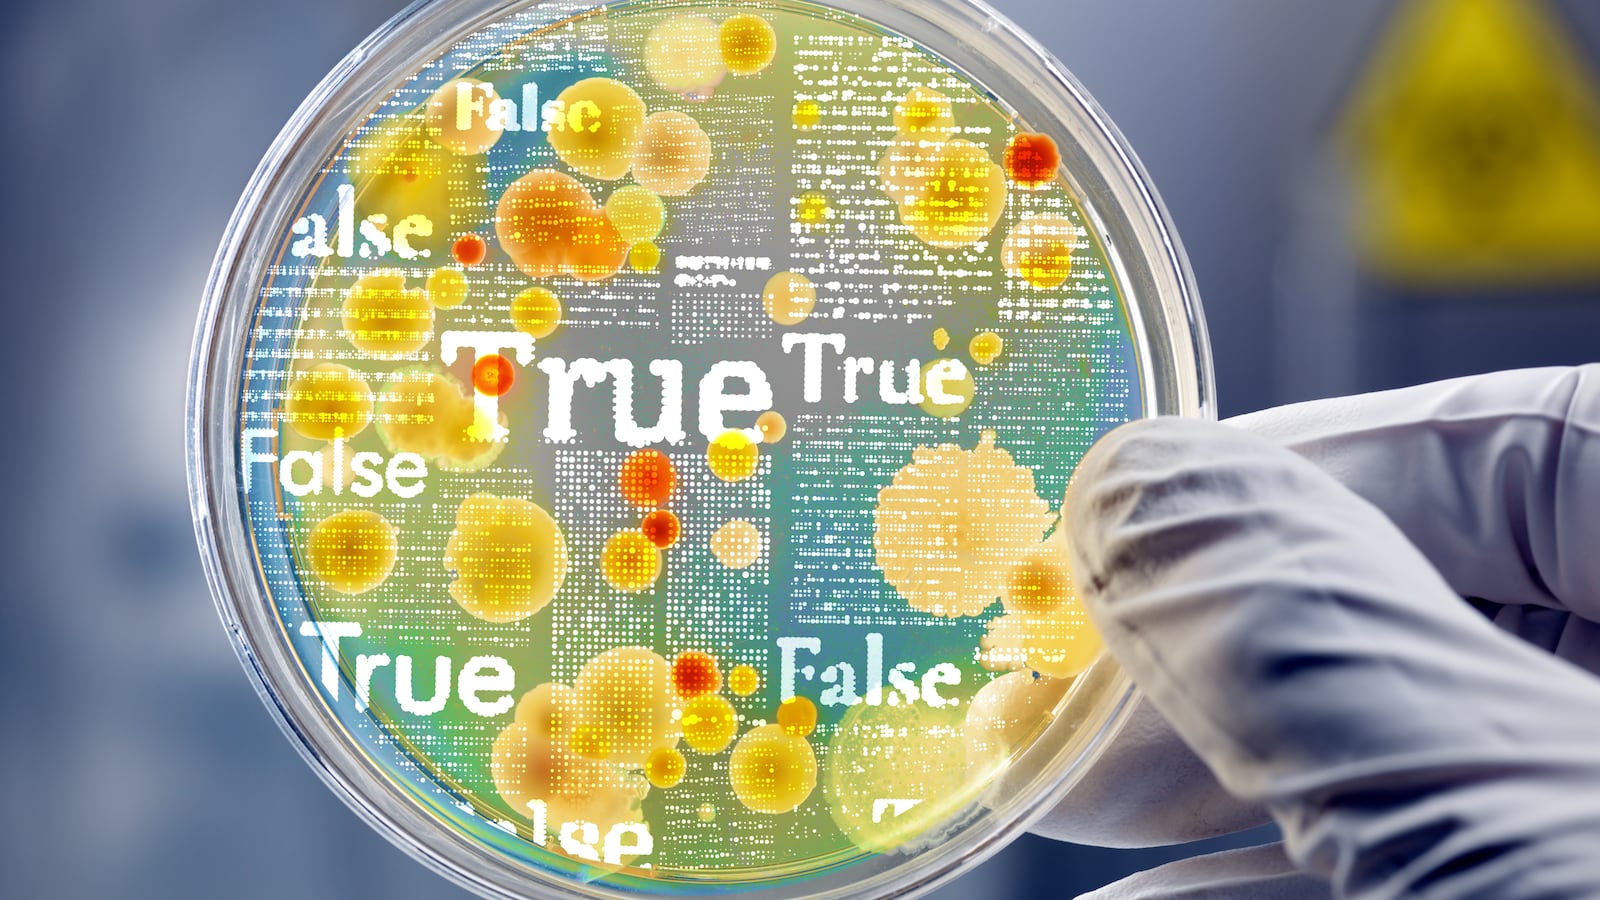
220821-medical-misinfo-hero_dtf0pc

Reports of polio found in New York City wastewater are setting off alarms, and casting new light on a big problem in America: the dangers of health-care misinformation.
Just as false claims about COVID-19 have contributed to many people’s decisions to forgo vaccines for it, similar misinformation spread by the anti-vax movement has led some people to skip polio vaccines as well, leaving them potentially vulnerable to a life-threatening disease that was eradicated decades ago.
M Booth Health (where I work) has a new study that shows that the proliferation of health-care misinformation—which some researchers call a “misinfodemic”—has got even worse over the past year. It’s endangering patients and making health-care professionals’ work lives even harder. It’s also threatening public health—and, therefore, affecting all of us.
For the study, “The Pharma Brandemic,” we surveyed more than 1,000 demographically diverse adults across the United States, asking them about a wide range of health care-related issues. Some of the most striking discoveries involve the extent to which false information is becoming an inevitable part of every aspect of the medical system. The overwhelming majority of respondents (88 percent) have encountered health-care misinformation, and nearly three-quarters (73 percent) are anxious about it. More than 1 in 3 believe they come across false health information almost every day— rising to 40 percent of African Americans and 39 percent of Gen Z.
Separately, we also surveyed 101 full time health-care providers. Almost all (99 percent) of them said they have patients share misinformation every week, and 90 percent of medical professionals are anxious about this. Nearly half (48 percent) say they now have less confidence that patients will comply with their recommendations. Perhaps unsurprisingly, the same percentage of patients (48 percent) say they are now more comfortable challenging their doctor.
As a result, more than ever before, when a patient walks out the door or ends a telehealth session, doctors have little faith that they’ll take the necessary steps to protect and improve their health. After all, they’ve seen people get sicker, and even die, because they believed lies and conspiracy theories about their health. Take, for example, the deathbed regrets of people who not only turned down COVID vaccines, but mocked and verbally attacked those who were vaccinated.
Empowerment requires education
To be clear, there are good aspects to people taking their medical decisions into their own hands. Our research shows some bright spots.
More than half of respondents (51 percent) say they have read about clinical trial data and 41 percent say they’ve read a medical journal in the past year to learn more about treatments or vaccines. These figures are even higher among Gen Z—at 59 percent and 56 percent, respectively. Young adults are the biggest health-information hunters—but also the biggest doctor-defiers.
Of course, doctors are not always right. And having patients who want to advocate for themselves can be helpful. The doctors we have polled recognize this. Most are happy to have patients who want to learn more, and who come in committed to understanding everything from their ailments to the efficacy of various treatments. Only one in ten health-care providers told us they see patient empowerment as a pure negative.
The problem is that patients can get lost in a sea of good and bad information mixed together, from social media to advice passed on by friends over messaging apps and more.
Numerous reports show that sometimes, misinformed patients even toss insults and threats at health-care providers. It’s one of the factors fueling a departure of doctors and nurses from the industry, worsening the labor shortage in the sector.
Pharma brands can help
Our report shows that pharmaceutical companies have a unique opportunity to help tackle the misinfodemic. The historic rollout of COVID-19 vaccines has created a level of brand awareness for these companies that they’ve never had before. More than half of Americans now think of them as being similar to “lifestyle brands” like Amazon or Nike—a big jump from our previous survey a year ago.
People have developed favorites among big brands like Pfizer, Moderna, Johnson & Johnson, and AstraZeneca. And they want to hear from these companies. Fifty-eight percent of respondents told us that how a pharmaceutical company communicates with them is just as important as how effective its treatments are.
Pharma companies need to be active in reaching people across all sorts of channels. Many consumers we surveyed said they trust health information from online influencers, YouTube channels, podcasts, social media accounts, and more.
When these companies create videos, infographics, and other content that explains scientific ideas, people pay attention. Consumers also want to hear from the executives. Sixty-two percent of respondents told us they want to hear more from pharmaceutical brand leaders—a jump of 16 percentage points from our study a year ago.
This is a big moment for the pharmaceutical industry. Using their formidable marketing machines, these companies can partner with public health officials, patients and physicians to correct misinformation, equipping people with an understanding of what’s real and what’s bunk. The more they take up the mantle, the more people will be equipped with real scientific knowledge—and the threat to public health will dissipate.
Mark Westall is senior vice president for strategy, insight and innovation at M Booth Health.